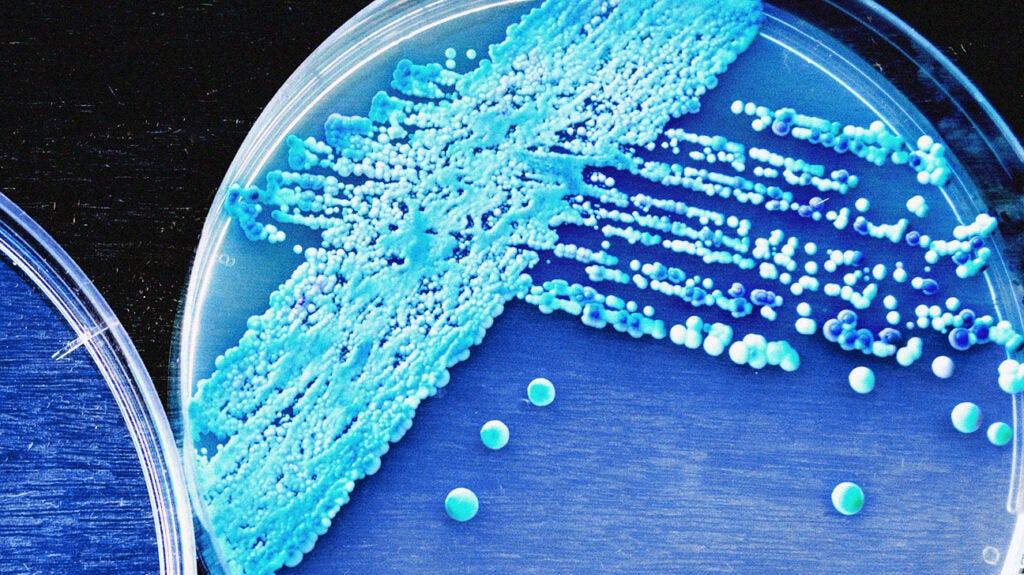
Oral thrush and HIV: What is the connection?

← oral thrush pictures images How to treat lingering oral thrush otc & medications oral thrush pictures baby Treating mom when baby has thrush →
If you are looking for Oral Thrush Hiv you've visit to the right page. We have 35 Images about Oral Thrush Hiv like Oral thrush.. hiv? : r/HIV, Oral thrush and HIV: What is the connection? and also Oral Thrush Pictures: What does Oral Thrush look like?. Here you go:
Oral Thrush Hiv
 ar.inspiredpencil.com
ar.inspiredpencil.com
Oral Thrush.. Hiv? : R/HIV
 www.reddit.com
www.reddit.com
Oral Thrush: 10 Symptoms Of Oral Thrush
 www.10faq.com
www.10faq.com
thrush oral symptoms next
How To Get Rid Of Oral Thrush
 schematicbloedrooijed.z21.web.core.windows.net
schematicbloedrooijed.z21.web.core.windows.net
Oral Thrush Nursing Interventions
 provalijamcqdblearning.z13.web.core.windows.net
provalijamcqdblearning.z13.web.core.windows.net
You Are HIV Positive If You See This 11 Signs - Must Read And Get
 www.mzansistories.com
www.mzansistories.com
hiv positive signs if tested must read get when
Everything You Need To Know About Oral Thrush - Willows Dentistry
 willowsdentistry.co.uk
willowsdentistry.co.uk
thrush oral everything need know
Oral Thrush: Symptoms, Causes, Treatment, And Diagnosis | FindATopDoc
 www.findatopdoc.com
www.findatopdoc.com
thrush oral symptoms remedies contagious medical findatopdoc adults candidiasis adult hiv condition like caused treatment
Oral Thrush Symptoms, Causes, Treatment, Prevention - Dr. Axe
 draxe.com
draxe.com
HIV/AIDS Oral Manifestations Images - HIV
 www.hiv.va.gov
www.hiv.va.gov
hiv oral thrush manifestations erythematous aids credits va
Oral Thrush Hiv Timeline, How Do You Treat A Vaginal Yeast Infection
 s3.amazonaws.com
s3.amazonaws.com
hiv oral yeast infection timeline thrush candida vaginal risk disease assessment assist guidance progression some
When Do Hiv Mouth Sores Appear ? - YouTube
 www.youtube.com
www.youtube.com
Oral Thrush Hiv
 ar.inspiredpencil.com
ar.inspiredpencil.com
Oral Thrush And HIV: What Is The Connection?
www.medicalnewstoday.com
www.medicalnewstoday.com
Oral Thrush Illustration - 326118587 : Shutterstock
 www.shutterstock.com
www.shutterstock.com
thrush oral infection candidiasis tongue causes symptoms candida yellow oropharyngeal std lips white fungal yeast gums teeth men adults infections
Signs Of Thrush In Women
 eslargirshollessonmedia.z21.web.core.windows.net
eslargirshollessonmedia.z21.web.core.windows.net
Oral Thrush Hiv
 ar.inspiredpencil.com
ar.inspiredpencil.com
What Is Oral Thrush And What Are Its Causes?
 www.smilepointdentalsanmateo.com
www.smilepointdentalsanmateo.com
Classification Of Oral Lesions Related To HIV [15]. | Download
![Classification of oral lesions related to HIV [15]. | Download](https://www.researchgate.net/publication/369640129/figure/tbl2/AS:11431281132324232@1680213641733/Classification-of-oral-lesions-related-to-HIV-15.png) www.researchgate.net
www.researchgate.net
Oral Thrush - YouTube
 www.youtube.com
www.youtube.com
Oral Thrush In Adults Home Treatment
 curinif48dblearning.z14.web.core.windows.net
curinif48dblearning.z14.web.core.windows.net
Throat Lozenges For Oral Thrush Cheap Sale | Www.aikicai.org
 www.aikicai.org
www.aikicai.org
Oral Candidiasis (Thrush) | Dermatology Oasis
 dermatologyoasis.net
dermatologyoasis.net
oral thrush candidiasis comments
Oropharyngeal/oesophageal Candidiasis (also Known As Oral Thrush)
 www.mymed.com
www.mymed.com
thrush oral candidiasis oropharyngeal oesophageal candida known also
What Is Thrush In Infants
 hukanjima4lfdblearning.z13.web.core.windows.net
hukanjima4lfdblearning.z13.web.core.windows.net
Hiv Rash Arms
 mavink.com
mavink.com
Signs Of Thrush In Babies
 avijacijej8ldblearning.z13.web.core.windows.net
avijacijej8ldblearning.z13.web.core.windows.net
Oral Thrush Hiv
 ar.inspiredpencil.com
ar.inspiredpencil.com
Oral Thrush Pictures: What Does Oral Thrush Look Like?
 www.findatopdoc.com
www.findatopdoc.com
oral thrush infection yeast what does look mouth lips like symptoms fungus white called
Hiv Bumps On Tongue
 proper-cooking.info
proper-cooking.info
Thrush Causes And Symptoms In Babies
 hukanjima4lfdblearning.z13.web.core.windows.net
hukanjima4lfdblearning.z13.web.core.windows.net
How To Use Nystatin For Thrush
 classvertidotoxico4i4q.z21.web.core.windows.net
classvertidotoxico4i4q.z21.web.core.windows.net
Oral Thrush Hiv
 ar.inspiredpencil.com
ar.inspiredpencil.com
Oral Thrush Hiv
 ar.inspiredpencil.com
ar.inspiredpencil.com
View 18 Oral Thrush Symptoms Women - Basevalueimage
:max_bytes(150000):strip_icc()/thrush-overview-2633410_final-b5e4aef9345d44ea8302630324f7d41b.png) basevalueimage.blogspot.com
basevalueimage.blogspot.com
How to use nystatin for thrush. Signs of thrush in women. Oral thrush